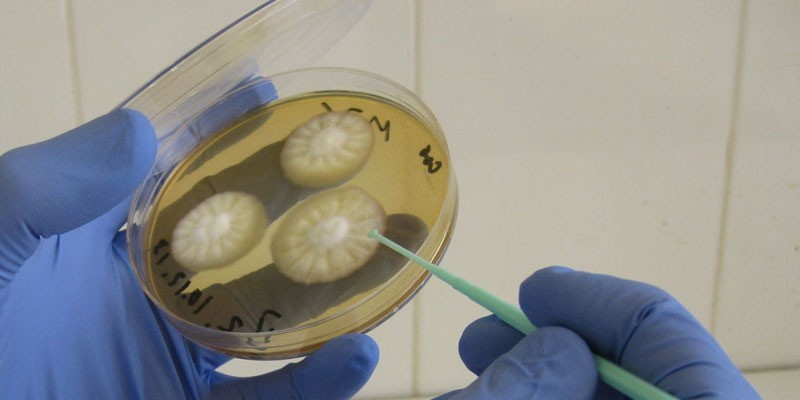
image

Среди заразных и трудноизлечимых заболеваний одно из первых мест занимают грибковые инфекции. Они диагностируются при поражении кожи, слизистых оболочек, ногтей или волос болезнетворными грибками. Эти возбудители могут годами жить на теле человека даже под влиянием лекарств. Большинство таких болезней связаны с ослабленным иммунитетом.
Что такое грибковые заболевания человека
К таким заболеваниям относится группа инфекций, при которых происходит заражение организма человека грибком. Возбудитель может размножаться на теле, лице, конечностях и даже во внутренних органах, например, легких или кишечнике. Существуют разные виды грибка, которые отличаются средой обитания:
- Зоофильные (Microsporum galinae, Microsporum nanus, Microsporum rivalieri, Microsporum persicolor). В этом случае источник заражения грибковыми заболеваниями – домашние или бездомные животные.
- Геофильные (Microsporum gypseum, Aspergillus fumigatus и Aspergillus niger, Cryptococcus neoformans). Живут только на растениях или земле. Заражение ими возможно при работе на дачных участках.
- Антропофильные (Candida, Microsporum audouinii, Trichophyton rubrum, Trichophyton tonsurans, Trichophyton violaceum, Microsporum langeroni). Их средой обитания является только человек.
- Зооантропофильные (Microsporum canis). Могут обитать как на животных, так и на человеке.
- Актиномицеты, или лучистые грибы. Они являются промежуточным звеном между истинными грибками и бактериями. Их область обитания – злаковые, включая ячмень, рожь, пшеницу и пр.
Мнение врачей:
Грибковые заболевания являются распространенной проблемой, с которой сталкиваются многие пациенты. Симптомы таких заболеваний могут варьироваться в зависимости от их типа и места поражения, но обычно они включают зуд, покраснение, шелушение кожи или ногтей. Для успешного лечения грибковых инфекций важно обратиться к дерматологу для точного диагноза и назначения соответствующей терапии. Лечение обычно включает применение антимикотических препаратов в виде мазей, кремов или таблеток.
Профилактика грибковых заболеваний также играет важную роль. Врачи рекомендуют соблюдать правила гигиены, избегать ношения общей обуви, своевременно лечить любые поражения кожи или ногтей. Также важно следить за состоянием иммунитета и правильно подбирать обувь и носить носки из натуральных материалов. Все эти меры помогут предотвратить возникновение грибковых инфекций и сохранить здоровье кожи и ногтей.

Причины
Основная причина таких болезней – это размножение на коже или слизистых тех или иных типов грибка. По отношению к человеку они делятся на два основных вида:
- Условно-патогенные, или сапрофитирующие: Мукор, Пенициллы, Аспергиллы. Они являются причиной эндогенного заражения, т. е. инфицирование ими происходит изнутри. Такие грибы размножаются только при благоприятных условиях, например, при снижении иммунитета.
- Патогенные: Кандиды, Трихофитоны, Дерматофиты, Криптококки, Микроспорум. Попадают в организм из окружающей среды, после чего начинают размножаться, чем и вызывают микозы.
В благоприятных условиях сапрофитирующие грибки прорастают в вегетативную форму. В ней они размножаются, питаются веществами из тканей организма, образуют новые споры. В этот период и появляется грибковая инфекция. Заразиться ею можно в следующих местах:
- массажном, педикюрном или маникюрном кабинете;
- банях;
- бассейнах;
- саунах;
- тренажерных залах.
Размножение возбудителя сопровождается выделением продуктов его жизнедеятельности. Они и вызывают у человека общие и местные аллергические или токсические реакции. Они проявляются в виде воспаления и интоксикации. Передача этого возбудителя возможна следующими путями:
- Алиментарным. Заражение происходит во время приема пищи, на который были споры гриба.
- Контактным. Человек может инфицироваться при прямом или непрямом контакте с больным. В последнем случае заражение происходит при пользовании обувью, одеждой и другими личными вещами заболевшего.
- Половым. Передача инфекции осуществляется во время сексуального контакта, причем источником может служить не только уже заболевший человек, но и носитель грибка.
- Воздушно-пылевым. Криптококки и аспергиллы способны длительное время сохраняться в окружающей среде и попадать в легкие при вдыхании спор.
Основная причина начала размножения условно-патогенных грибов – ослабленный местный или общий иммунитет. Выделяются и другие факторы риска заражения грибковыми инфекциями:
- недостаточная гигиена;
- длительное применение антибактериального или агрессивного мыла;
- ношение тесной обуви;
- нарушения нервной и эндокринной системы;
- ВИЧ и другие виды иммунодефицита;
- хронические инфекции;
- повышенная температура или влажность окружающей среды;
- неправильно проведенная эпиляция;
- травмы кожных покровов;
- беременность;
- детский или пожилой возраст.

Классификация
Определенные типы грибов могут проникать на разную глубину кожи или слизистых. С учетом этого фактора выделяют следующие виды грибковых заболеваний:
- Поверхностные микозы(кератомикозы): трихоспория, разноцветный лишай, узловатая трихоспория (пьедра). Грибок размножается только на коже или слизистых, не проникая во внутренние органы.
- Дерматофитии: эпидермофития, микроспория, парша (фавус), руброфития, трихофития, фаус. При таких болезнях грибки локализуются более глубоко в коже.
- Глубокие микозы: криптококкоз, хромомикоз, пенициллиоз, аспергиллез, споротрихоз, гистоплазмоз, бластомикоз, кандидоз. Они являются системными заболеваниями, поскольку грибок в организме распространяется по внутренним органам через кровоток.
- Псевдомикозы: эритразма, актиномикоз, подмышечный трихомикоз. Эти болезни вызваны микроорганизмами, которые находятся между бактериями и грибами – коринебактериями. При этих патологиях возможны некротический распад тканей и органов с образованием свищей.
Заболевания грибковой природы отличаются не только по глубине проникновения грибка. Другая классификация делит такие инфекции на виды в зависимости от места размножения возбудителя. С учетом этого фактора выделяют:
- Грибок волосистой части головы. Сюда относятся микроспория и трихофития. Очаги инфекции при таких болезнях появляются в зоне роста волос на лице и голове.
- Грибок ногтей – онихомикоз. Возбудитель размножается на ногтевых пластинах пальцев рук или ног.
- Грибок гладкой кожи. Очаги воспаления отмечаются на стопах, ладонях и других частях тела, где мало волос.

Опыт других людей
Грибковые заболевания вызывают немало беспокойства у людей, так как они могут быть не только неприятными, но и вызывать серьезные осложнения. Симптомы грибковых инфекций могут проявляться разнообразно: зуд, покраснение кожи, шелушение, появление пузырей. Лечение грибковых заболеваний требует терпения и дисциплины, обычно включая применение антимикотических мазей или пероральных препаратов. Однако, помимо лечения, важно также обратить внимание на профилактику: соблюдение гигиены, ношение обуви в общественных местах, своевременное лечение травм и повреждений кожи. Люди, столкнувшиеся с грибковыми инфекциями, рекомендуют обращаться к врачу при первых признаках и не откладывать лечение на потом.
Симптомы грибка
Каждый вид грибковой инфекции имеет определенную клиническую картину. Они зависят не только от типа грибка, но и от локализации и степени тяжести очагов поражения. На кожные микозы указывают следующие признаки:
- выпадение и ломкость волос при поражении волосистой части головы;
- шелушащиеся или мокнущие пятна и бляшки разной формы, размеров и с характером границ;
- покраснение или обесцвечивание кожных покровов;
- слияние множественных пятен в одно при прогрессировании недуга;
- гиперкератоз – ороговение кожи на участке поражения;
- зуд в зоне воспаления.
На фоне ослабленного иммунитета к грибковым инфекциям могут присоединиться бактериальные. В результате к общим симптомам добавляется сыпь с гнойным содержимым. При разрешении инфильтрата образуются мокнущие корочки, а затем – рубцы. При поражении грибком ногтей (онихомикозе) появляются другие признаки:
- утолщение ногтевой пластины, появление на ней пятен, полос, борозд;
- изменение цвета ногтя на желтый, серый, коричневый или черный;
- мокнутие или шелушение, зуд кожи в межпальцевых промежутках;
- хрупкость ногтевой пластины, крошение при обрезании;
- полное отделение ногтя при длительном течении инфекции.
Кератомикоз
В группу кератомикозов относятся болезни, связанные с поражением грибком рогового слоя кожи или кутикулы волоса. Такие инфекции менее контагиозные. Виды кератомикозов:
- тропический белый и желтый лишай;
- черепицеобразный микоз;
- отрубевидный лишай;
- пьедра;
- трихоспория;
- черный и белый лишай;
- узловатая трихоспория;
- шимбери.
При кератомикозах в патологический процесс не вовлекаются кожные придатки, поэтому воспалительные явления полностью отсутствуют. Такие инфекции никогда не затрагивают ногтевые пластины. Из кератомикозов чаще встречаются:
- Разноцветный лишай. Возбудитель – Malassezia furfur. Этот грибок является причиной перхоти, может вызывать себорею и атопический дерматит. Инфицирование таким лишаем возможно при усиленном потоотделении или изменении pH потожировой мантии. Это происходит при увеличении влажности или температуры окружающей среды. Основной симптом заболевания – пятна кофейно-молочного цвета на светлой коже или белого на темной. Они появляются на спине, груди, шее, плечах и в подмышечных впадинах. В области пятен наблюдаются повышенная потливость и сильный зуд.
- Узловатая трихоспория. Еще называется пьедрой, которая имеет две клинические формы: белую и черную. Возбудитель заболевания – Trichosporum hortai Brumpt. Основной симптом – появление на волосистой части головы мелких узелков веретенообразной, круглой или овальной формы. Они имеют гладкую или шероховатую поверхность. Количество узелков – от 2 до 50. Каждый охватывает волосяной фолликул в виде кольца. Узелки плотные и твердые на ощупь.
Дерматофитии
Более глубоко в слои кожи грибок проникает при дерматофитиях. Такие инфекции вызывают уже и воспалительные явления, поскольку затрагивают кожные придатки. Виды дерматофитии:
- микроспория;
- фавус, или парша (скутулярная, сквамозная, импетигинозная);
- руброфития;
- эпидермофития;
- трихофития.
Один из характерных признаков дерматофитии – аллергические реакции, или аллергиды. При микозах они называются микидами. Грибы в области их локализации отсутствуют. Аллергические проявления отмечаются на некотором расстоянии от грибковых поражений. Микиды делятся на несколько видов:
- дисгидрозиоформные;
- пятнисто-папулезные;
- лихеноидные;
- в форме нодулярной эритемы.
Статьи по теме
- Грибок на руках – симптомы и проявления заболевания, медикаментозная и народная терапия, осложнения
- Грибок в носу у человека: симптомы и лечение
- Грибок кожи головы – симптомы и виды, медикаментозная и народная терапия, профилактические меры
Возбудитель при дерматофитиях может поражать не только кожу, но и волосы или ногти. Из всех слоев кожного покрова в патологический процесс вовлекается преимущественно эпидермис. Из дерматофитий особенно распространены:
- Эпидермофития. Ее возбудитель – Epidermophyton. В своей группе этот гриб является единственным представителем. Инфицирование им возможно при ношении чужой обуви, посещении общественной бани или душа, на пляжном отдыхе. Выделяют эпидермофитию стоп и паховую. В первом случае заболевание протекает в дисгидротической, сквамозной, гиперкератолитической или интертригинозной форме. Основной симптом – мелкие пузыри на коже между пальцами, которые при вскрытии образуют эрозии, окруженные фестончатым валиком. Все это сопровождается неприятным мышиным запахом от ног. При паховой эпидермофитии в складках области паха образуются расположенные симметрично очаги, окруженные валиками из отдельных мелких чешуек, корочек или пузырьков.
- Руброфития. Развивается из-за поражения грибом Trichophyton rubrum. Это заболевание более тяжелое по сравнению с предыдущим. Грибок размножается на стопах, кистях, ногтях. Общий симптом руброфитий – зуд в области поражения. Другой характерный признак – гиперкератоз, т. е. сухость и муковидное шелушение участков кожи. Вероятность развития руброфитии высока при приеме антибиотиков, гормональных средств или летом из-за повышенной потливости.

Кандидоз
Это одна из самых распространенных групп грибковых инфекций. Их возбудитель – грибок рода Candida. Вызванные им инфекции еще называют молочницей из-за характерного белого творожистого налета преимущественно на слизистых оболочках. Существуют следующие виды кандидоза:
- Поверхностный. Грибы размножаются на слизистых оболочках или коже.
- Генерализованный. Поражает внутренние органы: мочеполовые, репродуктивные, дыхательные, пищеварительные.
- Висцеральный. Грибы при таком заболевании распространяются, как на кожных и слизистых покровах, так и во внутренних органах.
Грибы рода Кандида считаются условно-патогенным, поскольку они являются частью микрофлоры человека и вызывают заболевания только при определенных условиях, чаще – на фоне ослабления иммунитета. В зависимости от вида кандидоза возбудитель может поражать:
- слизистые оболочки;
- кожные складки;
- гладкую кожу;
- ногти;
- пространство между пальцами;
- бронхи;
- мышцы;
- печень;
- селезенку;
- кровеносные сосуды;
- почки;
- мозговую ткань;
- желудок;
- кишечник.
Глубокие микозы
В эту группу входят системные заболевания, связанные с грибковым поражением слизистых оболочек, кожных покровов и внутренних органов. Виды глубоких микозов:
- риноспоридоз;
- кокцидиомикоз;
- мадуромикоз;
- споротрихоз;
- бластомикоз;
- аспергиллез;
- гистоплазмоз;
- хромомикоз.
Перечисленные заболевания могут развиваться на фоне сильного угнетения иммунной системы, нарушения гормонального фона, сбоя в процессах обмена веществ. Основными среди глубоких микозов являются:
- Бластомикоз. Возбудители – диморфные грибы: дрожжевые, которые почкуются в коже и внутренних органах, и нитчатый мицелий. Симптомы зависят от формы бластомикоза. Европейский вызывает узелки в коже и паренхиматозных органах, южноамериканский – нагноение лимфоузлов, свищи на поверхности лица и шеи, североамериканский – гнойные очаги в подкожной клетчатке и внутренних органах.
- Гистоплазмоз. Возбудитель – гриб Histoplasma capsulatum. Заражению чаще подвержены люди, живущие в странах с влажным климатом, преимущественно африканских и азиатских. Среди всех форм этого заболевания преобладает гистоплазмоз легких. Симптомы: кашель, слабость, боль в груди, лихорадка в течение 2 недель, одышка, высокая температура, тошнота и рвота.
Диагностика
Первым этапом диагностики выступает сбор анамнеза и выяснение жалоб пациента. Далее врач проводит объективное внешнее обследование для выявления грибка поверхностного слоя кожи. Из лабораторных и инструментальных методов диагностики микозов выделяются:
- Люминисцентное свечение. С помощью одноименной лампы врач может обнаружить мицелий грибка на коже – он будет давать синеватое отсвечивание.
- Культуральный посев. Это выращивание в специальных питательных средах культур, обнаруженных в соскобе с кожи или слизистых больного. Проводится для подтверждения грибка и выявления типа возбудителя.
- Рентгенография. Используется при глубоком грибковом поражении. Помогает подтвердить грибок в легких по темным пятнам в их области на снимке.
- Магнитно-резонансная и компьютерная томография (МРТ и КТ). Необходимы для точного определения локализации и типа изменений во внутренних органах.
Лечение грибковых заболеваний
Инфекции грибковой природы считаются трудноизлечимыми. Определенная схема терапии выбирается с учетом типа возбудителя, локализации и тяжести очагов поражения. Лечение грибковой инфекции в организме направлено на подавления роста и размножения грибов. Дополнительно принимаются меры по устранению симптомов заболевания. Для этих целей применяют следующие группы препаратов:
- Противогрибковые, или антимикотические: Флуконазол, Тербинафин, Кетоконазол, Миконазол, Низорал, Нистатин. Они обладают фунгицидными и фунгистатическим действиями, т. е. подавляют размножение грибов и приводят к гибели их клеток.
- Иммуномодуляторы: Виферон. Этот препарат стимулирует иммунитет, поэтому используется при ослаблении защитных механизмов.
- Сульфаниламиды: Стрептоцид, Бисептол, Ко-тримоксазол. Эти антибиотики при грибковых заболеваниях используются для блокирования метаболизма возбудителя. Чаще применяются при наличии гнойно-воспалительных процессов на коже.
- Антисептические: Мирамистин, жидкость Бурова, масло чайного дерева, препараты йода, Хлоргексидин. Активные компоненты этих лекарств взаимодействуют с белками грибов, оказывая на них противогрибковый эффект.
- Кортикостероиды: Клотримазол, Белосалик. Помогают справиться с сильными воспалительными реакциям, связанными с выделением продуктов жизнедеятельности гриба.
На ранних стадиях инфекций лечение проводится местно, в более запущенных случаях – добавляют системные препараты. В первом случае используют спреи, растворы, мази, гели, лаки, шампуни. К наружным методам терапии также относятся противогрибковые пластыри. При системной терапии назначают прием внутрь таблеток или капсул. Схема лечения подбирается индивидуально с учетом локализации и площади очага поражения:
- для лечения микозов волосистой части головы используют кератолитические средства в виде шампуней;
- для подсушивания мокнущих очагов инфекции на коже на ночь их обрабатывают йодом, а утром – салициловой мазью;
- при нагноениях корки снимают и тоже проводят обработку салициловой мазью;
- при кандидозе половых органов у женщин проводят спринцевания и вагинально вводят противогрибковые свечи или тампоны (их смачивают травяными отварами или лекарственными растворами);
- в случае обширного поражения ногтя его удаляют хирургическим путем.
Препараты системного действия
К средствам системного действия относятся таблетки и капсулы для приема внутрь. На ранней стадии грибка и при небольших площадях поражения их не используют. В этом случае применяют местные средства, которые имеют меньше побочных эффектов. Если такие лекарства не справляются с грибком, то назначают таблетки. Они воздействуют на возбудителя изнутри. Примеры системных антимикотиков:
- Нистатин. Это антибиотик полиенового ряда с противогрибковой активностью. Препарат повышает осмолярность внутри грибковой клетки, вызывая ее гибель. Показание к применению – кандидоз внутренних органов, кожи и слизистых и его профилактика после длительной антибиотикотерапии. Дозировка для приема внутрь – 500 тыс. ЕД 6–8 раз в сутки на протяжении 14 дней. Противопоказания: беременность, гиперчувствительность к нистатину, нарушение функции печени, панкреатит, язва желудка. Побочные реакции: рвота, тошнота, горький привкус во рту, боль в животе, диарея, озноб.
- Гризеофульвин. Угнетает процессы деления грибковых клеток, вызывая их гибель. Показания к применению: онихомикозы, фавус, трихофития, микроспория, эпидермофития. Гризеофульвин принимают внутрь с 1 ч. л. растительного масла. Дозировка зависит от заболевания. Противопоказания: порфирия, поражения почек и печени, сахарный диабет, лейкопения, злокачественные новообразования, беременность и лактация. Возможные побочные эффекты: диспепсия, головные боли, головокружение.
- Орунгал. Тормозит синтез эргостерина в стенке грибковых клеток, вызывая их гибель. Показан при дерматомикозах, кандидамикаозах, отрубевидном лишае, висцеральных глубоких кандидозах, онихомикозах, системных микозах. Дозировка Орунгала определяется видом заболевания. Побочные эффекты и противопоказания препарата многочисленны, поэтому их стоит уточнить в подробной инструкции к нему.
Средства для наружного применения
На первом этапе грибковые заболевания кожи, слизистых или ногтей лечат посредством местной терапии. Ее преимущество в том, что наружные средства воздействуют преимущественно в области локализации гриба. На ранней стадии это более эффективный метод лечения. Примеры местных противогрибковых препаратов:
- Ламизил. Это мазь, которая подавляет синтез стеринов в грибковой клетке. Она показана при микозах стоп, гладкой кожи, паховой эпидермофитии, разноцветном лишае, опрелостях, вызванных плесневыми грибами. Мазь наносят 1–2 раза в сутки на тщательно очищенный участок кожи, затрагивая небольшие здоровые области рядом. Лечение длится 1–2 недели. Противопоказания: повышенная чувствительность к составу Ламизила. Среди побочных эффектов возможны аллергические реакции в месте нанесения.
- Жидкость Бурова. Оказывает противовоспалительное и антибактериальное действия. Показание к применению – снятие воспалительного процесса на коже и слизистых. В стакане воды нужно растворить 2 ст. л. жидкости Бурова. Этим раствором проводят обработку очагов поражения 1–2 раза день. Противопоказание – гнойные инфекции. Побочные реакции отсутствуют.
- Низорал. Активный компонент этого шампуня нарушает синтез эргостерола в грибковой клетке, приводя к ее гибели. Показания к применению: отрубевидный лишай, перхоть, себорейный дерматит. Шампунь используют во время мытья головы: наносят на 4–5 минут, после чего смывают водой. Частота применения зависит от заболевания. Противопоказание – индивидуальная чувствительность к составу Низорала. Из побочных эффектов возможно развитие эритемы, раздражения, контактного дерматита, ощущения жжения, алопеции.
- Леворин. Эта мазь усиливает проницаемость мембраны грибковой клетки, стимулируя ее лизис. Показание к применению Леворина – десенсибилизирующая терапия при грибковых поражениях эпидермиса, слизистых оболочек, женских половых органов. Проблемные участки нужно смазывать 1–2 раза в день на протяжении 5–7 суток. Возможные побочные реакции: сильный зуд, покраснение, раздражение в месте нанесения. Леворин противопоказан при почечной и печеночной недостаточности, панкреатите, язве желудка, беременности, лактации, острых заболеваниях пищеварительного тракта, высокой чувствительности к составу препарата.
- Салициловая мазь. При грибковых инфекциях используется как дополнение к основному лечению. Мазь обладает антисептическим и противовоспалительным действиями. Показания к применению: псориаз, хроническая экзема, ихтиоз, дискератозы, воспалительные заболевания кожи. Наносить мазь на очаги поражения нужно до 3 раз в сутки. После процедуры возможно появление кожного зуда, жжения, высыпаний. Противопоказана мазь при индивидуальной гиперчувствительности к салициловой кислоте и в младенческом возрасте.

Народные рецепты
Эффективность народных средств отмечается только в сочетании с традиционной терапией. По поводу их применения стоит проконсультироваться с врачом, поскольку некоторые ингредиенты рецептов могут вызвать аллергию, что ухудшит состояние. Примеры эффективных народных средств:
- Смешать равные пропорции тысячелистника, подорожника, листьев лопуха, полыни. Взять 1 ст. л. сбора, залить стаканом кипятка. Дать средству настояться, процедить, после чего вылить в тазик с умеренной горячей водой. Выдержать в ванночке ступни 15–20 минут. Повторять 2–3 раза за сутки до исчезновения симптомов заболевания. Вместо отвара трав в воду можно просто добавить 1–2 ч. л. соды. Рецепт эффективен при грибке стопы.
- Измельчить 3–4 зубика чеснока, добавить 2 ч. л. сливочного масла, перемешать смесь до получения однородной консистенции. Смазывать пораженные участки ежедневно перед сном на протяжении 1 недели.
- Взять свой шампунь, добавить в него 2–3 ч. л. масла орегано, взболтать емкость. Мыть этим средством волосы каждый день до исчезновения симптомов грибковой инфекции волосистой части головы.
Профилактика грибковых заболеваний
Практически любое заболевание можно предотвратить. Это проще, чем потом заниматься длительным лечением. Основой профилактикой грибковых инфекций является соблюдение правил личной гигиены. Ни в коем случае нельзя пользоваться вещами больного грибком. Исключить контакт нужно с его обувью, одеждой, полотенцами, посудой, предметами личной гигиены. Другие меры профилактики:
- избегать контакта с бездомными животными;
- при наличии домашних питомцев регулярно посещать с ними ветеринара;
- во время примерки обуви в магазинах использовать подследники;
- в бане, сауне, на пляже не ходить босиком;
- лечить имеющиеся хронические заболевания.
Видео
Внимание!
Информация, представленная в статье, носит ознакомительный характер. Материалы статьи не призывают к самостоятельному лечению. Только квалифицированный врач может поставить диагноз и дать рекомендации по лечению, исходя из индивидуальных особенностей конкретного пациента.
Статья обновлена: 05.06.2018
Частые вопросы
Как понять что у тебя грибок в организме?
Признаки грибковой инфекции определяются типом возбудителя, его локализацией, а также тяжестью инфекции. Заболевание вызывает зуд, покраснение, шелушение или образование пузырьков.
Как лечить грибковую инфекцию в организме?
Лечение грибковых инфекций состоит в применении противогрибковых препаратов. В зависимости от тяжести, вида инфекции могут назначаться препараты в форме инъекций, таблеток, мазей, кремов, растворов для местного применения. Продолжительность курса терапии определяется лечащим врачом.
Какие болезни вызывают грибок?
Кератомикозы (разноцветный лишай, пьедра и др.)Дерматофитии (эпидермофития, трихофития, микроспория, рубромикоз и др.)Кандидоз (поверхностный кандидоз кожи и слизистых оболочек, висцеральный кандидоз)Глубокие микозы (споротрихоз, хромомикоз)Псевдомикозы (эритразма, актиномикоз).
Как выглядит грибковая инфекция на коже?
Кожа в месте поражения краснеет и шелушится, на ней появляются узелки и мелкие бугорки. При поражении кожи туловища образовывает большие пятна покрасневшей кожи с ярко-красными концентрическими валиками. Микроспория.
Полезные советы
СОВЕТ №1
При первых признаках грибкового заболевания (зуд, покраснение, шелушение кожи) обратитесь к дерматологу для точного диагноза и назначения эффективного лечения.
СОВЕТ №2
Помните, что самолечение грибковых инфекций может усугубить проблему. Не используйте антигрибковые препараты без консультации врача.
СОВЕТ №3
Для профилактики грибковых заболеваний следите за гигиеной ног, избегайте ношения обуви из синтетических материалов и посещайте общественные места в домашней обуви.



